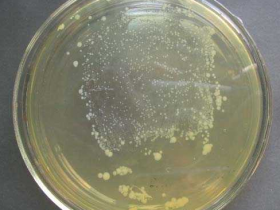
酵母感受态细胞的制备和保存

酵母双杂交系统(Yeast two hybrid,Y2H)是一种常用的方法,用于研究两种蛋白质之间的相互作用。通过将两种蛋白质分别克隆到酵母表达质粒中的转录激活因子的DNA结合结构域(DNA-BD)和转录激活域(AD)上,构建成融合表达载体,可以实现对这两种蛋白质相互作用的分析。
pGBKT7是一种酵母双杂交bait表达载体,旨在表达GAL4 DNA结合结构域(DNA-BD,1-147 aa)与bait蛋白质的融合蛋白。而pGADT7则是另一种酵母双杂交表达载体,用于表达GAL4激活结构域(AD, 768-881 aa)与目的蛋白的融合蛋白。这种系统提供了一种有效的工具,可以帮助研究人员深入了解蛋白质间的相互作用机制。

一、酵母感受态细胞制备
(1) 将-80℃保存的酵母菌株在YPDA固体培养基平板上划线,30℃培养条件下倒置培养4-7d。
(2) 挑取单菌落至含3mLYPDA液体培养液中。
(3) 30℃培养,200rpm 震荡培养8h。
(4) 当菌液OD值约为0.3时,转移10uL菌液到含50mIYPDA培养液中。
(5) 30℃培养,200rpm震荡培养16-20h至OD值为015-0.3。
(6) 700g转速5min室温离心收集细胞。
(7) 将底部沉淀使用已预热至30℃的100mLYPDA中重悬酵母细胞。
(8) 30℃,200rpm,摇3-5h至OD值=0.6时。
(9) 5min室温离心收集细胞。
(10) 将底部沉淀在30mL无菌超纯水中重悬酵母细胞.
(11) 700g转速5min室温离心收集细胞。
(12) 将底部沉淀加入3mL的1.1XTE/LiAc重悬细胞。
(13) 将悬重悬细胞分成2管,6000g转速室温离心30s。
(15) 将底部沉淀加入500uL的1XTE/LiAc重悬酵母细胞,分装为100uL每管。
二、转化
(1)在干净的1.5 mL的离心管中并振荡混匀。
(2)每个离心管中加入100 µL的酵母感受态细胞,500 µL的PEG/LiAc溶液,加入两种质粒,并且将管中的混合物进行旋涡振荡,将其混匀。
(3)在30℃,220 rpm/min的摇床振荡培养30 min。
(4)往每个离心管中加70 µL的DMSO,并温和的上下颠倒混匀。将离心管在42℃水浴中热激40 min(每隔10 min摇匀1次)。
(5)取出离心管,在冰上静置2 min。
(6)吸取100 µL并涂布在相应的二缺固体培养基上,培养3-4天,待菌长好后,挑单菌落于10ulYPDA液体培养基中,30℃培养过夜。
互作验证:
取过夜培养的菌液涂布于四缺平板上,将培养皿置于30℃恒温培养箱中培养,观察是否生长与颜色变化。
注意事项:
(1)检测感受态细胞效率,标准操作规范。
(2)注意质粒使用量,检查仪器状态。
(3)配制新鲜培养基,并做对照转化,添加抑制剂,同时增设严格的对照组防止自激活。
(4)应挑选大的、新鲜的菌株克隆进行培养。